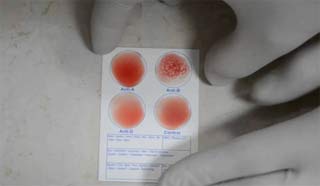
проба крови

Суть метода
Поскольку гемотрансфузия представляет собой процесс пересадки чужого биоматериала, полностью идентичную кровь, которая совпадала бы по всем антигенным системам, найти практически невозможно. Поэтому в настоящее время цельная кровь используется крайне редко.
Для снижения риска осложнений и отторжения донорскую кровь чаще всего разделяют на компоненты, такие как плазма и эритроцитарная масса. Полученный от донора биоматериал сначала помещается на карантинное хранение, где он подвергается обработке при низких температурах.
Кровь может храниться в холодильнике до 20 дней, в течение которых сохраняются ее полезные свойства. Однако следует помнить, что красные кровяные клетки не переносят замораживания, так как это может привести к повреждению их оболочки.
Основные функции крови, попадающей в организм пациента, включают:
- гемостатическую;
- заместительную;
- дизинтоксикационную;
- питательную;
- стимулирующую.
Гемотрансфузию необходимо проводить с особой осторожностью, строго следуя технике переливания и только после анализа на совместимость. Любое необдуманное решение может вызвать серьезные осложнения, вплоть до летального исхода для пациента.
Переливание крови — это сложная медицинская процедура, требующая высокой квалификации специалистов. Врачи подчеркивают, что перед началом процедуры необходимо провести тщательное обследование пациента и определить его группу крови. Это критически важно для предотвращения возможных осложнений.
Процесс начинается с подготовки донорской крови, которая проходит тестирование на наличие инфекций и совместимость с реципиентом. Затем кровь помещается в специальный контейнер и нагревается до оптимальной температуры. Врачи отмечают, что во время переливания необходимо внимательно следить за состоянием пациента, чтобы вовремя выявить возможные аллергические реакции или другие негативные последствия.
После завершения процедуры медики продолжают наблюдение за пациентом, чтобы убедиться в отсутствии осложнений. Таким образом, переливание крови — это не только технический процесс, но и важный этап в лечении, требующий профессионализма и внимательности.
https://youtube.com/watch?v=Xcq_02gKZcU
Показания
Процедура переливания крови назначается довольно часто. К основным показаниям для ее проведения относятся:
- Значительная потеря крови, которая может привести к анемии и угрожать жизни пациента. Если потеря превышает 30% объема крови, уровень гемоглобина снижается, а артериальное давление падает, поэтому восстановление утраченной жидкости необходимо осуществить как можно скорее.
- Операции, в ходе которых происходит потеря мягких тканей.
- Продолжающееся кровотечение.
- Тяжелая анемия.
- Шоковое состояние, вызванное травмой.
Существуют и относительные показания к переливанию, когда данная процедура выступает в качестве дополнительного метода:
- Гемолитические расстройства.
- Заболевания, сопровождающиеся образованием гнойных очагов и внутренними воспалениями.
- Интоксикация организма химическими веществами.
- Ожоги мягких тканей, особенно в тяжелой форме.
- Подготовка к операции.
- Нарушения в работе внутренних органов.
- ДВС-синдром, при котором необходимо переливание плазмы.
- Длительное применение антикоагулянтов непрямого действия.
- Недостаток определенных компонентов в собственной крови.
При относительных показаниях в 50% случаев вместо переливания крови назначается введение отдельных ее компонентов, в зависимости от конкретной патологии.
| Этап переливания крови | Действие | Важные моменты/Меры предосторожности |
|---|---|---|
| Подготовка донора | Медицинский осмотр, анализ крови (группа, резус-фактор, инфекции), заполнение анкеты, гидратация | Исключение противопоказаний (беременность, инфекционные заболевания, низкий гемоглобин и др.), соблюдение правил асептики и антисептики |
| Забор крови | Взятие крови из вены с использованием стерильной системы | Строгое соблюдение правил асептики, контроль за состоянием донора, правильное маркирование образцов |
| Обработка и хранение крови | Разделение крови на компоненты (эритроциты, плазма, тромбоциты), тестирование на инфекции, хранение в специальных условиях | Соблюдение температурного режима, сроки хранения компонентов крови, контроль качества |
| Подготовка реципиента | Определение группы крови и резус-фактора, тестирование на совместимость (проба на совместимость), мониторинг состояния | Точное определение группы крови и резус-фактора, проведение проб на совместимость обязательно, контроль за состоянием пациента перед процедурой |
| Переливание крови | Внутривенное введение компонентов крови с использованием специальной системы | Медленное введение, постоянный мониторинг состояния пациента (пульс, давление, дыхание), наблюдение за возможными реакциями |
| Последующее наблюдение | Мониторинг состояния пациента в течение нескольких часов после переливания | Выявление и лечение возможных побочных реакций (лихорадка, аллергические реакции, гемотрансфузионный шок) |
Виды гемотрансфузии
Медицинские специалисты делят переливание крови на основе двух основных критериев: метода выполнения и способа введения.
Существует несколько типов гемотрансфузии:
- Непрямое переливание. В этом случае пациенту вводят определенные компоненты донорской крови, такие как плазма, эритроциты или лейкоцитарная масса.
- Прямое переливание. Биоматериал передается непосредственно от донора к реципиенту. Эта процедура выполняется с использованием шприца или специального аппарата.
- Обменное переливание. Обычно назначается при почечной недостаточности или гемотрансфузионном шоке. Из организма пациента изымается определенное количество крови, которое затем заменяется донорской в том же объеме.
- Аутогемотрансфузия. Это процесс переливания собственной крови пациента, которая была собрана за несколько часов до операции.
По способам введения выделяют следующие методы переливания:
- в вену (наиболее распространенный метод);
- в аорту;
- в костный мозг;
- в артерию.
Переливание крови — это процедура, о которой многие имеют свои мнения и представления. Некоторые люди считают, что это сложный и рискованный процесс, требующий высокой квалификации медиков. Другие, напротив, уверены, что переливание — это стандартная практика, которая спасает жизни. Многие отмечают, что перед процедурой важно пройти тщательное обследование, чтобы исключить возможные осложнения.
Существуют и мифы: кто-то думает, что переливание может изменить личность или характер человека. Однако врачи уверяют, что это всего лишь заблуждение. Важно также отметить, что донорство крови — это благородный поступок, который помогает не только в экстренных ситуациях, но и при плановых операциях. Люди, которые стали донорами, часто делятся положительными эмоциями и гордостью за то, что смогли помочь другим. В целом, общественное мнение о переливании крови разнообразно, но большинство согласны с тем, что это важная и необходимая медицинская практика.
https://youtube.com/watch?v=EWNyu5kwlJ8
Подготовка
Для того чтобы избежать осложнений у детей и взрослых, перед проведением процедуры необходимо провести тщательную подготовку.
Первым шагом является определение резус-фактора пациента, после чего следует установить группу крови. Только после получения этих данных можно начинать поиск подходящего донора.
Кроме того, врачу необходимо провести ряд исследований, чтобы установить наличие хронических заболеваний или противопоказаний у пациента.
Если это возможно, за 48 часов до переливания рекомендуется взять образец крови пациента для проведения биологических проб и тестов на возможные аллергические реакции.
Проведение проб
Перед тем как приступить к переливанию донорской крови или биоматериала, полученного из контейнера, медицинский работник обязан провести контрольные тесты. Это требование является обязательным.
- Тест на резус-фактор. Если при смешивании донорской крови и биоматериала реципиента наблюдается агглютинация, переливание запрещено.
- Тест на индивидуальную совместимость. Венозная кровь пациента смешивается с цитратом натрия, а затем в нее добавляется биоматериал донора. Если возникает агглютинация, процедуру нельзя продолжать.
- Биологический тест. В начале переливания жидкость вводится постепенно. Если пациент не испытывает дискомфорта и неприятных ощущений, можно продолжать процедуру. В случае появления болей в пояснице или озноба необходимо немедленно прекратить переливание.
https://youtube.com/watch?v=Z2x61-ZQ4XE
Совместимость групп
Система переливания крови была разработана давно. Крайне важно, чтобы группы крови донора и пациента совпадали, иначе проведение процедуры строго запрещено.
- Группа 1 считается универсальной и может быть перелита людям с группами 1, 2, 3 и 4.
- Группа 2 подходит для пациентов с 2 и 4 группами.
- Группа 3 может быть использована для людей с 3 и 4 группами.
- Группа 4 предназначена исключительно для пациентов с 4 группой.
Перед началом процедуры переливания донорской крови врач также должен проверить соответствие резус-фактора.
Как осуществляется процедура
Во время гемотрансфузии медицинский специалист обязан тщательно следовать всем установленным нормам. Если это возможно, пациенту стоит узнать, проводилась ли ранее подобная процедура и как организм отреагировал на введение донорской крови.
Переливание у взрослых
Алгоритм действий при проведении процедуры остается неизменным. Как только совместимость подтверждена, можно переходить к самой операции.
Перед началом вмешательства необходимо достать контейнер с донорским биоматериалом и в течение 40 минут держать его при температуре окружающей среды (в случае наличия определенных показаний контейнер следует подогреть до 37 градусов).
Для введения биоматериала применяется одноразовая система переливания, оборудованная специальным фильтром. Скорость введения донорского материала составляет 40-60 капель в секунду.
В процессе процедуры врач обязан внимательно следить за состоянием пациента и при возникновении дискомфорта или ухудшения самочувствия немедленно остановить вмешательство. Полное переливание крови из контейнера не допускается; небольшое количество биоматериала должно остаться в клинике и храниться в течение 2 суток для возможности проведения необходимых анализов в случае необходимости.
Переливание у детей
Как осуществляется гемотрансфузия у детей? Процесс переливания крови проходит по тем же принципам. Эта процедура выполняется исключительно при наличии четких медицинских показаний, так как детский организм более чувствителен и может начать отторгать донорский биоматериал.
Важно отметить, что при переливании крови детям не применяют биоматериал от родственников, поскольку это увеличивает риск заражения инфекциями.
Противопоказания
Медицинская практика показывает, что переливание крови является крайне серьезной процедурой, которая может привести к осложнениям и ухудшению состояния пациента. Даже при подтвержденной совместимости образцов существует вероятность отторжения.
Перед началом процедуры врачи должны тщательно оценить противопоказания к переливанию и выяснить, не страдает ли пациент от следующих заболеваний:
- артериальная гипертензия 3 степени;
- нарушения работы сердца;
- проблемы с кровообращением и сосудистые патологии;
- аллергические реакции;
- дисбаланс белков в организме;
- гнойные воспалительные процессы в сердечной мышце.
Процедуру не следует проводить, если у пациента ранее возникали осложнения после переливания, а также при наличии злокачественных опухолей.
Возможные осложнения
При проведении гемотрансфузии могут возникнуть различные негативные последствия. Чаще всего они связаны с несовместимостью кровяных компонентов и ошибками медицинского персонала, такими как неправильное хранение или нарушение протоколов во время процедуры.
Наиболее часто встречающиеся осложнения включают в себя:
- повышение температуры и озноб;
- цианоз;
- проблемы с дыханием и удушье;
- резкие колебания артериального давления;
- тахикардию и аритмию;
- инфаркт легкого;
- развитие острого почечного недостатка.
Для минимизации риска подобных осложнений во время переливания необходимо, чтобы медицинский работник внимательно следил за состоянием пациента и фиксировал все изменения. Рекомендуется, чтобы процедуру проводил опытный специалист с достаточной квалификацией.
Перед тем как приступить к переливанию, важно не только провести множество анализов на совместимость и определить показания, но и тщательно оценить все преимущества и недостатки данной процедуры. Следует помнить, что гемотрансфузия может как способствовать восстановлению здоровья пациента, так и усугубить его состояние, вплоть до фатальных последствий.
Вопрос-ответ
Как делают переливание своей крови?
Классическая аутогемотерапия предполагает подкожное или внутримышечное введение пациенту его собственной свежей венозной крови, не подвергнутой каким-либо воздействиям и не смешанной с какими-либо веществами. Чаще всего у пациента берут кровь из вены и вводят её глубоко внутримышечно в верхненаружный квадрант ягодицы.
Что чувствует человек во время переливания крови?
Помимо повышения температуры, человек может чувствовать озноб, а также (в некоторых случаях) головную боль или боль в спине. Кроме того, иногда у человека могут возникать симптомы аллергической реакции, такие как зуд или сыпь.
Советы
СОВЕТ №1
Перед переливанием крови обязательно проконсультируйтесь с врачом. Он оценит ваше состояние здоровья и определит необходимость процедуры, а также подберет подходящий донорский материал.
СОВЕТ №2
Убедитесь, что в медицинском учреждении соблюдаются все стандарты безопасности и стерильности. Это поможет избежать возможных осложнений и инфекций.
СОВЕТ №3
Обратите внимание на возможные побочные эффекты. После переливания крови важно следить за своим состоянием и сообщать врачу о любых необычных симптомах, таких как лихорадка или аллергические реакции.
СОВЕТ №4
Если вы планируете стать донором крови, ознакомьтесь с требованиями и противопоказаниями. Это поможет вам подготовиться к процедуре и убедиться, что вы подходите для донорства.